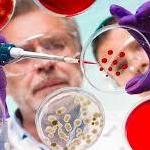
Anna

Son Güncellemeler
-
The Preclinical Foundation: How Obesity Models Drive Therapeutic BreakthroughsThe global escalation of metabolic disorders has transformed obesity from a secondary health concern into a primary clinical challenge, necessitating a more sophisticated approach to pharmaceutical intervention. While the ultimate goal of any therapeutic is successful human application, the high rate of attrition in clinical trials underscores the critical need for a robust preclinical...0 Yorumlar 0 hisse senetleri 46 Views 0 önizlemePlease log in to like, share and comment!
-
Obesity Models: The Essential Tools Unlocking Next-Generation TreatmentsThe global obesity epidemic presents a paradox of modern science: it is one of the world's most prevalent and costly health crises, yet it remains profoundly complex and challenging to treat. For decades, the struggle against obesity has been hampered by a fundamental disconnect—attempting to address a multifaceted disease of dysregulated metabolism, systemic inflammation, and intricate...0 Yorumlar 0 hisse senetleri 37 Views 0 önizleme
-
0 Yorumlar 0 hisse senetleri 15 Views 0 önizleme
Daha Hikayeler